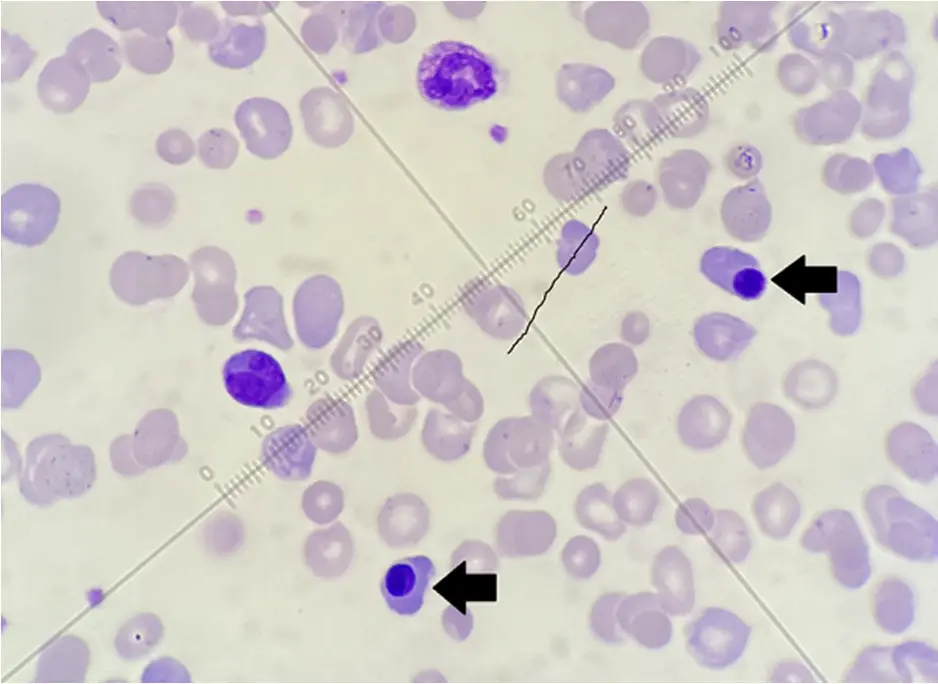
圖片

115年:(醫檢)血液(1)
周邊血液抹片經 Giemsa染色如下圖,下列何者最可能是箭頭所指的細胞?
Anucleated RBC
Bsmall lymphocyte
Cmonocyte
Dplasma cell
詳細解析
本題觀念:
本題考查周邊血液抹片(Peripheral Blood Smear)中**有核紅血球(Nucleated RBC, nRBC)**的型態辨識能力,特別是區分其與小型淋巴球(Small lymphocyte)的差異。這在臨床血液學檢驗中是非常基礎且重要的技能,因為成人周邊血出現 nRBC 通常暗示著病理狀態。
影像分析:
- 背景細胞:視野中充滿了成熟紅血球(RBC),部分紅血球呈現多色性(Polychromasia,帶藍灰色),暗示骨髓造血活躍。
- 箭頭所指細胞:
- 細胞大小:與周圍的成熟紅血球大小相近或略大。
- 細胞核:呈現極度緻密、深染(Deeply stained)、固縮狀(Pyknotic)的圓形核,核質均勻深紫黑色,幾乎看不到染色質結構,這是晚期紅血球前驅細胞的典型特徵。
- 細胞質:顏色呈現粉紅色至橘紅色(Acidophilic/Orthochromic),與周圍成熟紅血球的血紅素顏色非常接近,顯示細胞質內已充滿血紅素。
- 綜合特徵:此細胞為正鐵紅血球母細胞(Orthochromic Normoblast),即晚期的有核紅血球。
選項分析:
-
A. nucleated RBC (有核紅血球):正確。
- 箭頭所指細胞具有典型的固縮核(pyknotic nucleus),且細胞質含有血紅素(呈現粉紅色/橘色),符合 Orthochromic Normoblast 的特徵。在 Giemsa 染色下,這是 nRBC 最顯著的辨識點。
-
B. small lymphocyte (小型淋巴球):錯誤。
- 小型淋巴球的細胞核雖然也緻密,但通常仍可見塊狀染色質結構(clumped chromatin),不會像此圖中那樣完全呈現均質的黑紫色固縮狀。
- 最關鍵的區別在於細胞質顏色:淋巴球的細胞質應為天藍色(sky blue),且不含血紅素;而圖中細胞質呈現粉紅/橘色(與 RBC 同色),排除了淋巴球的可能性。
-
C. monocyte (單核球):錯誤。
- 單核球體積通常最大(直徑約 12-20 μm),遠大於紅血球。
- 其細胞核呈腎形、馬蹄形或不規則摺疊狀,且染色質疏鬆呈蕾絲狀(lacy chromatin),細胞質為灰藍色並常帶有空泡(vacuoles),與圖中特徵完全不符。
-
D. plasma cell (漿細胞):錯誤。
- 漿細胞的特徵是**深藍色(Deep blue)**的細胞質(因富含粗糙內質網),且核旁會有明顯的亮區(perinuclear hof)。
- 其細胞核雖偏一邊(eccentric),但染色質呈車輪狀(cartwheel pattern)排列,而非圖中的固縮狀。
答案解析
圖中箭頭所指細胞具有固縮且緻密的圓形細胞核,且細胞質顏色呈現血紅素的粉紅色調,這是有核紅血球(Nucleated RBC),具體來說是正鐵紅血球母細胞(Orthochromic Normoblast)的典型特徵。雖然其大小與小型淋巴球相似,但透過細胞質顏色(粉紅 vs 天藍)與核的緻密程度(固縮 vs 塊狀)可輕易區分。故選 (A)。
核心知識點:
- nRBC vs Lymphocyte 鑑別口訣:
- nRBC:核極度黑(固縮)、質粉紅(含血紅素)。
- Lymphocyte:核塊狀(可見結構)、質天藍(不含血紅素)。
- 臨床意義:
- 除了新生兒外,周邊血液出現 nRBC 通常是**異常(Pathologic)**的。
- 常見原因:嚴重的溶血性貧血(Hemolytic anemia)、骨髓受到壓力(如缺氧、大出血)、或骨髓浸潤性疾病(Myelophthisis,如癌症骨轉移、纖維化),導致骨髓屏障受損,未成熟細胞釋出。
- 檢驗報告若發現 nRBC,必須校正白血球計數(WBC count),因為自動血液分析儀常誤將 nRBC 算作淋巴球,導致偽性白血球增高(Pseudoleukocytosis)。
參考資料
- Rodak's Hematology: Clinical Principles and Applications.
- Clinical Hematology Atlas.